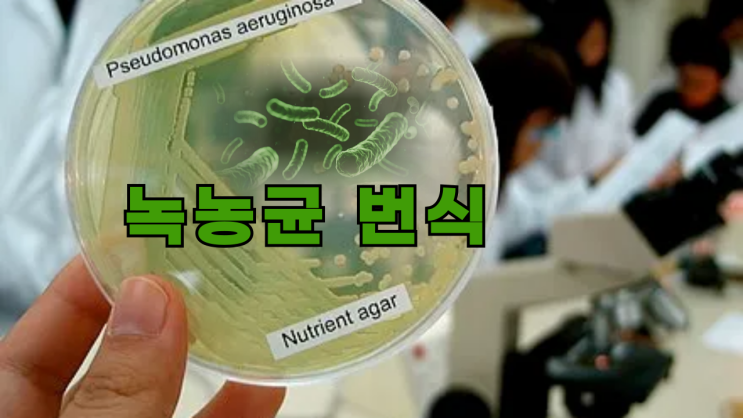

샴푸성분 유해성 심층분석 보습제 피부컨디셔닝제
2025.07.31

샴푸 성분 분석 및 설명 좋은 샴푸는 무엇일까? 유해성 있는 샴푸는 또 잇을까? 나에게 맞는 샴푸는 있을까...
출처
https://blog.naver.com/changsoo2023/223474486247
이슈모어 핫이슈
-
 풍자 다이어트 성공 이후 반응 폭발…새 프로필 공개되자 완전히 달라진 비주얼 화제
풍자 다이어트 이후 달라진 비주얼이 온라인에서 큰 화제를 모으고 있다. 방송인 풍자는 최근 자신의 SNS를 …
풍자 다이어트 성공 이후 반응 폭발…새 프로필 공개되자 완전히 달라진 비주얼 화제
풍자 다이어트 이후 달라진 비주얼이 온라인에서 큰 화제를 모으고 있다. 방송인 풍자는 최근 자신의 SNS를 …
-
 김희철 아는형님 휴식 선언 뒤 달라진 얼굴…팬들 안심시킨 최근 근황
김희철 아는형님 이슈가 다시 팬들의 관심 중심에 섰다. JTBC 대표 장수 예능 ‘아는 형님’에서 잠시 휴식…
김희철 아는형님 휴식 선언 뒤 달라진 얼굴…팬들 안심시킨 최근 근황
김희철 아는형님 이슈가 다시 팬들의 관심 중심에 섰다. JTBC 대표 장수 예능 ‘아는 형님’에서 잠시 휴식…
-
 써니 욕배틀녀 류혜린 결혼 조용히 전한 소식에 다시 소환된 장면들
써니 욕배틀녀로 강한 인상을 남겼던 배우 류혜린이 결혼 소식을 전하며 다시 화제를 모으고 있다. 영화 ‘써니…
써니 욕배틀녀 류혜린 결혼 조용히 전한 소식에 다시 소환된 장면들
써니 욕배틀녀로 강한 인상을 남겼던 배우 류혜린이 결혼 소식을 전하며 다시 화제를 모으고 있다. 영화 ‘써니…
관련 포스팅
Copyright blog.dowoo.me All right reserved.